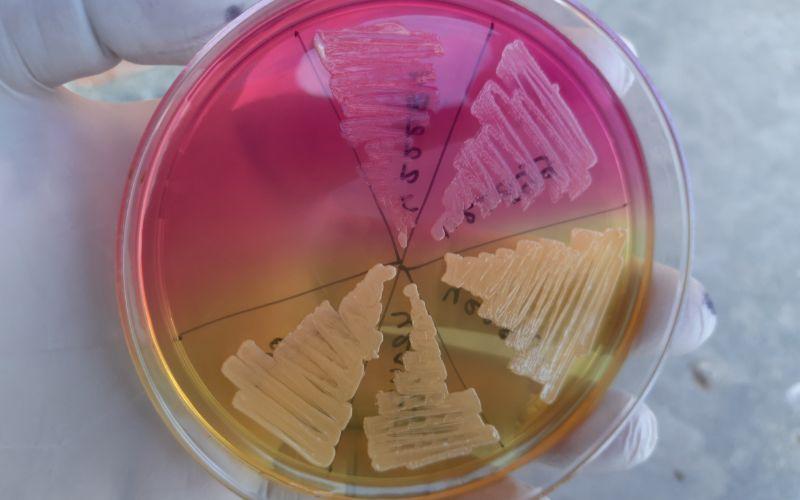

Among genus Staphylococcus, coagulase-negative Staphylococcus (CoNS) were the most common isolated species, with Staphylococcus xylosus as the most prevalent species (33.3%). Furthermore, Enterococcus spp. strains were isolated, and Enterococcus faecalis was the species showing the highest frequency of isolation (93.8%).. Staphylococcus aureusis gram positive, and showed Mannitol fermentation on Mannitol salt agar shown in (Fig. 1). Biochemical test performed are tabulated in (Table 1). All the isolates in our.
Agar sal y manitol qué es, fundamento, preparación, usos

Mannitol salt agar plate inoculated with Staphylococcus aureus. Yellow... Download Scientific

Mannitol Salt Agar Introduction, Composition, Preparation, Colony Charact
Lista 96+ Foto Staphylococcus Aureus En Agar Sal Y Manitol Cena Hermosa

Lista 96+ Foto Staphylococcus Aureus En Agar Sal Y Manitol Cena Hermosa

Know your Micromedia Mannitol Salt Agar (MSA) is a selective and differential media. The high

Staphylococcus Grown On Mannitol Salt Agar Foto de stock 1461765914 Shutterstock

Lista 96+ Foto Staphylococcus Aureus En Agar Sal Y Manitol Cena Hermosa

Lista 96+ Foto Staphylococcus Aureus En Agar Sal Y Manitol Cena Hermosa
Staphylococcus aureus on Mannitol salt agar MEDizzy

Lista 96+ Foto Staphylococcus Aureus En Agar Sal Y Manitol Cena Hermosa

Growth of Staphylococcus aureus on yolksalt agar with mannitol a. in... Download Scientific

Chemistry of Microbiology Lecture Materials from the Virtual Microbiology Classroom

Lista 96+ Foto Staphylococcus Aureus En Agar Sal Y Manitol Cena Hermosa
Staphylococcus on Mannitol Salt Agar Stock Photo Image of agar, mannitol 110190660

Mannitol Salt Agar Microbiology Images Photographs from Science Prof Online

Mannitol Salt Agar Microbiology Images Photographs from Science Prof Online

Lista 96+ Foto Staphylococcus Aureus En Agar Sal Y Manitol Cena Hermosa

Mannitol Salt Agar (MSA) Introduction, Composition, Principle, Test

1.1 Growth of Staphylococcus aureus on Mannitol Salt Agar (MSA) media. Download Scientific
El agar manitol salado es un medio selectivo usado para el aislamiento de estafilococos patógenos, especialmente Staphylococcus aureus, considerado un patógeno bacteriano serio desde que desarrolló resistencia a la penicilina en 1950. 1 El agar manitol salado ha sido empleado también en estudios de resistencia a antibióticos, en los cuales.. a la bacteria persistir en el huésped y en el ambiente, sobreviviendo a factores adversos, al sistema inmune y a los antimicrobianos. Palabras claves: Staphylococcus aureus, resistencia bacteriana, biopelícula, MSCRAMM, proteínas de unión a la fibronectina. Abstract Staphylococcus aureus is a microorganism characterized by being the main.